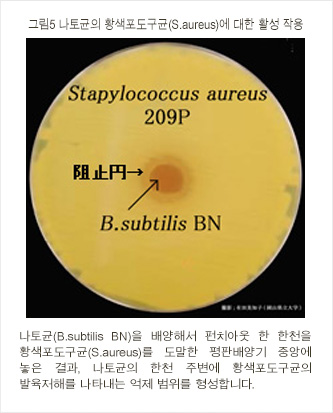
그림5 나토균의 황색포도구균(S.aureus)에 대한 활성 작용
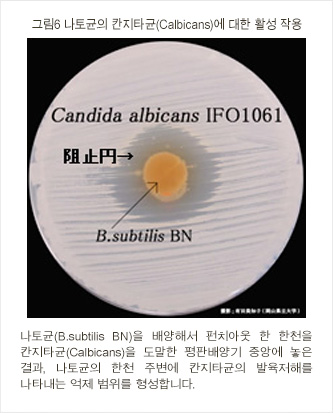
그림6 나토균의 칸지타균(Calbicans)에 대한 활성 작용

낫토균(그림1, 그림2)는 1906년에 사와무라 마코토 농학박사에 의해 발견되어 ‘Bacillus natto Sawamura’라고 명명되었습니다. 그 후, 1968년에 의약품제조승인, 1990년 동물용 의약품승인, 1996년 사료첨가물 허가를 취득해, 최근 건강식품으로써 이용하게 되어 주목받고 있습니다.
낫토균은 일본의 예로부터 실처럼 늘어나는 낫토, 네팔의 키네마(Kinema), 태국의 토우아나오(Thua-nao)등 무염발효대두식품을 만들어내는 균입니다. 엄밀한 의미로 장내에 항상 존재하는 균 이 아니라, 이른바 고초균의 일종으로, 내생포자(아포)를 갖는 자연계에서 가장 안정한 균종입니다.
낫토균은 장내에서 활성화되고, 여러 가지 생리작용을 나타내 각 동물이 본래 보유하고 있는 유익균군(유산균, 비피더스균 등)을 증강, 안정화합니다. 그 결과, 당연히 병원균이나 부패균 등의 유해균은 배제됩니다. 또한, 항균작용이 강해 Bacilipin이나 Subtilin등의 항균성물질을 만드는 것도 알려져 있습니다. 그 밖에, 최근 낫토균의 항암작용이나 면역기능 증강작용도 보고 되고 있습니다.
낫토균(B.subtilis BN)의 권장섭취량은 7.5X108개/일 입니다.
이것은 혼합배양에 의한 유산균 증식촉진, 장내의 유해균 및 병원균 증식 억제의 효과, 쥐(렛트)의 반복 경구 투여독성시험에 의해 안전성을 확인하고, 경제성 및 사용실적을 바탕으로 설정되었습니다.
![]()


![]()

![]()
